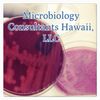

Laboratory Services
Inclusive Laboratory Testing
Inclusive Laboratory Testing
Inclusive Laboratory Testing
Total Aerobic Bacterial Count (quantitative)
Total Yeast and Mold Count (quantitative)
Total Coliform Count (quantitative)
Total Enterobacteraciae Count (qualitative)
Culture for identification (qualitative)
Foreign Materials
UPON APPROVAL:
Potency Cannabinoid Profiing
Residual Pesticides
Residual Solvents
Mycotoxins
Terpenes
Heavy Metals
Exclusive Laboratory Testing
Inclusive Laboratory Testing
Inclusive Laboratory Testing
Aspergillus fumigatus (screen)
Aspergillus flavus (screen)
Aspergillus Niger (screen)
Campylobacter sp. (screen)
Clostridium sp. (screen)
E.coli (screen)
E.coli, pathogenic STEC (screen)
Listeria monocytogenes (screen)
Pseudomonas aeruginosa (screen)
Salmonella sp. (screen)
Staphylococcus aureus (screen)
Staphylococcus aureus, mrsa (screen)
Vibrio species (screen)
Food Safety Microbiological Panel (screen)
Soil, Sterility and Other Testing
Soil, Sterility and Other Testing
Soil, Sterility and Other Testing
pH Level (qualitative)
Water Activity
Moisture Content
Water Sterility
(quant/qualitative)
Reagent Sterility
(quant/qualitative)
Air Sampling
(quant/qualitative)
Surface Sampling
(quant/qualitative)
Medical Device/Equipment (quant/qualitative)
Soil Sampling including nutrients
(quant/qualitative)
Product Recall-Culture for Contaminant
(quant/qualitative)
Veterinary Laboratory Testing
Soil, Sterility and Other Testing
Soil, Sterility and Other Testing
Urine Culture
Urinalysis with Reflex Culture
Mastitis Culture
S.aureus/MRSA Culture Screen
Stool Culture
Campylobacter Screen
VRE Culture Screen
Aerobic Culture
Anaerobic Culture
Fungus Culture
Cryptococcus/Giardia Screen
Tritrichomonas Screen
Courier Services
Environmental/Agriculture Studies
non-cannabis courier services- available

Standard Courier
Professional and prompt
Cannabis Studies
cannabis courier service -available

Registered Couriers
Couriers are screened for criminal background, fingerprinted, and registered. We deliver your product with peace of mind.
Courier service for cannabis products must be with a certified grower or dispensary. Does not apply to non-THC containing cannabis by-products i.e. cbd oils
Contact Us
info@aglabshawaii.com (New Clients)
omar@aglabshawaii.com (Marketing)
sherrie@aglabshawaii.com (Current Clients & Consulting)
AgLabs Hawaii LLC
Haiku, Hawaii 96708, United States
(808) 205-2802 (Current Clients, Consulting, Emergencies) (808) 446-2308 (New Clients)
Hours
Monday - Friday: 8:00am - 5:00pm
Saturday - 8:00am-12:00pm
Sunday: Closed
Our Partners
Copyright © 2024 AgLabs Hawaii LLC - All Rights Reserved.
*** PROVERBS 4:20 ***
